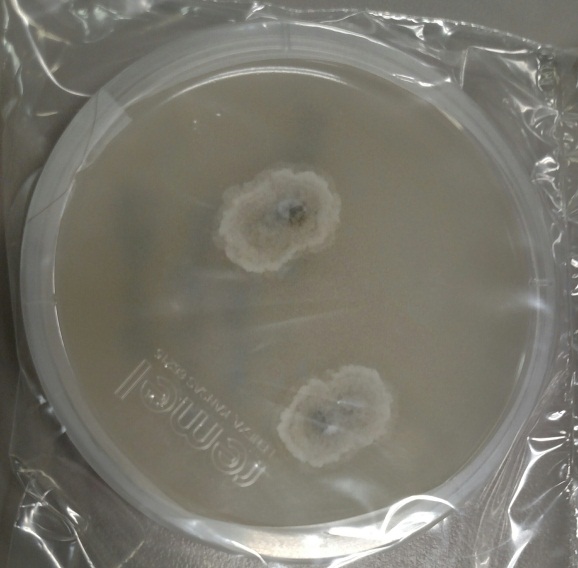
scedo1

Case History:
A previously healthy 30 year old man presents with a painful right eye. Three weeks before he had been cutting concrete with an electric saw when a piece of hard concrete hit him in the eye. The eye became painful the following day. He was treated with empiric antibiotics but the eye pain failed to improve. He was eventually seen by ophthalmology, where ophthalmologic exam demonstrated findings suspicious for fungal keratitis. Corneal scraping was performed and sent for bacterial and fungal culture.
Laboratory Identification:
Bacterial culture showed no growth. Fungal culture demonstrated rapid growth of multiple white, cottony molds on potato flake agar. Over time these white colonies turned dark grey/brown. The reverse surface of the agar was white at first but also turned dark grey/brown over time.
Microscopically (scotch tape preparation), there were thin hyphae with single conidia arising directly off the tips of tapered conidiophores of variable length. Occasional conidia were also observed arising directly off of the sides of hyphae. The conidia were small and oval in shape with a truncated base, and somewhat darker as compared to the surrounding hyphae. Sexual forms were not observed.

Discussion:
The clinical history and laboratory findings are characteristic of Pseudallescheria boydii/Scedosporium apiospermum.
Pseudallescheria boydii/Scedosporium apiospermum is an environmental mold which can be isolated from rural soils, polluted waters, manure and compost. Infection occurs secondary to local trauma. In immunocompetent individuals, infection is limited to the site of trauma, with some of the more common presentations being fungal keratitis, endophthalmitis, eumycotic mycetoma, sinusitis and pneumonia in the setting of near drowning. In immunocompromised individuals, infection can disseminate and involve any organ.
Pseudallescheria boydii/Scedosporium apiospermum is the most common cause of eumycotic mycetoma. Mycetoma is a chronic granulomatous infection of the subcutaneous tissue, usually involving the distal lower extremities, which can be caused by either a fungus (eumycotic mycetoma) or an actinomyces species bacteria (actinic mycetoma). On clinical exam there are multiple draining sinus tracts. The causative microorganisms aggregate into macroscopically visible groups (“granules”) which can be white, yellow or brown in color. Mycetoma may progress over time to involve underlying soft tissue, muscle, fascia and bone. Other less common causes of eumycotic mycetoma include Madurella spp., Acremonium spp., Fusarium spp., and Curvularia spp.
This organism has two names because historically different names were assigned to the sexual state (Pseudallescheria boydii) and to the asexual state (Scedosporium apiospermum). Morphologically, Pseudallescheria and Scedosporium are identical, the only difference being the presence of the sexual form, cleistothecia, in Pseudallescheria. Cleistothecia, when present, can be recognized as very large, dark-brown asci containing numerous ascospores. Technically, in the absence of cleistothecia the correct diagnosis would be Scedosporium boydii, however in clinical practice both names are usually listed regardless of whether cleistothecia are seen.
Pseudallescheria boydii/Scedosporium apiospermum is resistant to amphotericin B, but should be susceptible to azole therapy. The patient is being treated with topical voriconazole and oral fluconazole and currently (two weeks of antifungal therapy) has near complete resolution of symptomatology.
-Javier De Luca-Johnson, MD is a 3rd year anatomic and clinical pathology resident at the University of Vermont Medical Center.

-Christi Wojewoda, MD, is the Director of Clinical Microbiology at the University of Vermont Medical Center and an Assistant Professor at the University of Vermont.
How is he responding to medication, am interested
Good one!